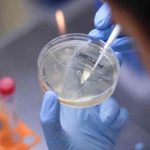
Vietnam detecta una nueva variante del coronavirus vietnam, nueva variante, covid-19-

Etiqueta: nueva variante
¡Alarma! En Estados Unidos detectan una peligrosa variante de gripe aviar
Confirmaron el hallazgo de una peligrosa variante de gripe aviar en una parvada de traspatio no comercial, confirmada por al menos ocho animales; en...
Omicron apunta nuevo síntoma: Los sudores nocturnos
El Covid 19, está evolucionando cada día más; estamos inmersos en una auténtica explosión de casos de una nueva variante del SARS-CoV-2 llamada Omicron;...
¿Cómo es la nueva y peligrosa variante del coronavirus detectada por Sudáfrica?
Una nueva variante del covid-19 ha puesto en alerta al mundo. Detectada primero en Sudáfrica y extendida ya a cinco países vecinos, la variante...
OMS en alerta por la nueva variante del COVID-19 que ya está en Europa
La Organización Mundial de la Salud (OMS) calcula que harán falta "varias semanas" para comprender el nivel de transmisión y la virulencia de la...
¡Otra más! Identifican nueva variante del covid-19 en Francia
Francia ha detectado varios casos de una nueva variante de COVID-19, lo que genera preocupación en medio de un aumento contagios de la enfermedad...
Detectan en Sudáfrica la variante del COVID «más mutada» hasta la fecha
Una nueva variante de coronavirus, que parece ser la más mutada hasta ahora, ha sido detectada en Sudáfrica, informa The Jerusalem Post citando un...
Vietnam detecta una nueva variante del coronavirus
Vietnam ha descubierto una nueva variante del virus de la COVID-19, que sería una combinación de las variantes india y británica; informaron el sábado...
Salud de El Salvador identifica nueve variantes del SARS-CoV-2
San Salvador, 7 ene (Prensa Latina) Los casos de Covid-19 se mantienen al alza hoy en El Salvador, donde el Ministerio de Salud identificó...
Identifican una «nueva variante» del coronavirus en el Reino Unido
Una "nueva variante" que se propaga con gran rapidez del SARS-CoV-2, el coronavirus que causa la covid-19, ha sido identificada en el Reino Unido,...